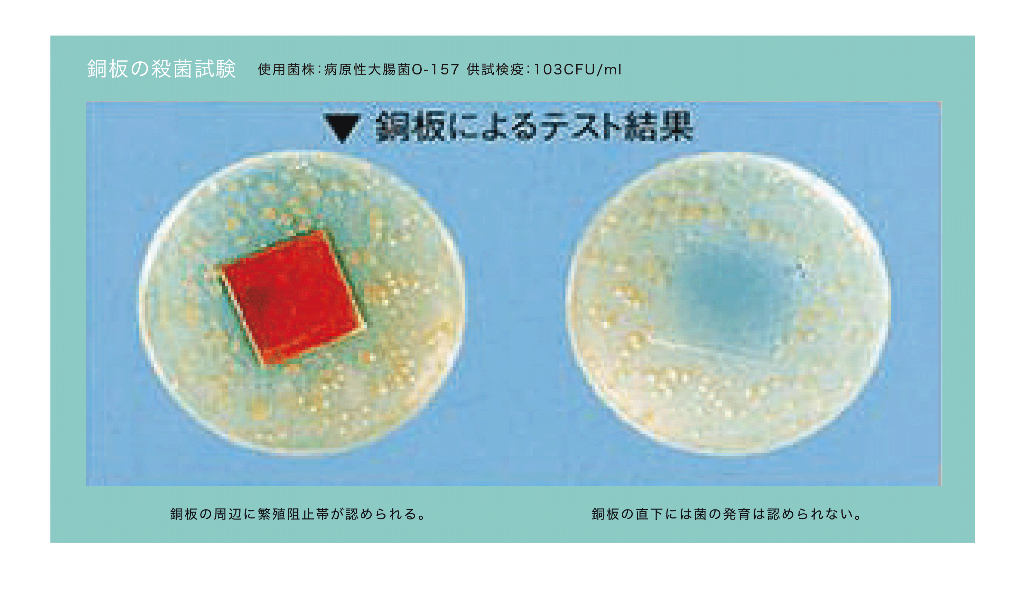

軽貨物配送
![軽貨物配送]()
軽貨物配送は、軽貨物(貨物運搬用の軽自動車)を使った運送・配送をする事業のことです。
業務の内容としては、軽トラックや、軽1BOXなどの軽車両を利用してお客様の荷物を配送・運送する仕事になります。
一般的に街中でよく見かける黄色いナンバープレートをつけた軽自動車とは違って、黒色に黄色い文字のナンバープレートをつけた軽自動車が軽貨物配送事業用の軽自動車となります。
通称「黒ナンバー」と呼ばれるナンバープレートで、この黒ナンバーが軽貨物運送事業(貨物軽自動車運送事業)で利用される車両の大きな特徴となります。
この業務を始めるにあたり、特別な資格などは必要なく普通免許さえ所持していれば、その他の資格は必要ありません。
また、会社員などとは大きく異なり、頑張れば頑張っただけご自身の収入につながり、高収入が目指せるのも魅力のひとつです。
しっかりとした研修制度を受けて業務に慣れてくれば、会社員の方の平均月収を超えるほどの収入を手に入れることが可能です。
“FLICKR PLUS(フリッカープラス)”の軽貨物配送は、未経験の方でも高収入を目指せる充実した研修制度が整っており、やる気次第で今までの月収を超えることが可能です。
また、現在”FLICKR PLUS”の軽貨物配送に従事している方のほとんどが、全く異なる業種から転職してきた方たちです。
“FLICKR PLUS(フリッカープラス)”では、配送の業務に従事した経験がない方でも、しっかりとした指導があり、勤務するためのサポートや日々のフォロー、情報交換なども充実しています。
光触媒コーティング
![光触媒コーティング]()
光触媒とは、二酸化チタンを主な成分として生まれた、コーティング剤のことをいいます。
二酸化チタンでコーティングされたものが、日光や照明などの光を受けると酸化還元反応が起こり、無害な水や二酸化炭素に分解されることによって、抗菌や空気の浄化、汚れの防止などの効果を発揮します。
二酸化チタンは食品や化粧品などに使用されているほど安全なものなので、酸化還元反応が起こってもそのもの自体の性質に変化はなく、人体への有害な影響もなく、安心安全に使用できることが光触媒の特徴です。
光合成とよく似た原理で、光合成をイメージしていただくとわかりやすいかもしれません。
光合成の場合では、植物が日光を受けると、葉緑素を触媒に光エネルギー(紫外線)を利用して水と二酸化炭素から酸素を生成します。
光触媒の場合では、酸化チタンという金属を触媒にして、光エネルギー(紫外線)を使用して空気中に存在する水と酸素から活性酸素を生成します。
この強力な酸化力を持つ活性酸素によって、有機化合物が二酸化炭素と水に分解されることで抗菌、脱臭、汚れ防止などの効果を発揮します。
日光を受ける外壁の塗料などに光触媒を使うことが多いですが、最近では室内の抗菌にも有効な方法と認識されており、さまざまな場所で利用されるようになりました。
室内で使用されているのは、空気中の酸素や水分と反応する無光触媒コーティング、照明の光など人工的な光にも反応する可視光型光触媒コーティングとなっております。
コロナ禍で除菌、抗菌への関心がより高まった今だからこそ、光触媒という言葉が浸透し、採用される企業や家庭が増えてきております。
01.What is a photocatalyst? ―光触媒って、何?
光が当たることにより、空気中の水分や酸素を引き寄せて、 ニオイや汚れなどの有機化合物を酸化分解する物質です。
その際に光触媒は化学変化しません。
光さえあれば効果を示すことから、環境にやさしい技術として 今まさに世界から注目されています。
光触媒は酸化チタン系光触媒です。
酸化チタンは白色の粉末で、顔料などとして 化粧品、食品添加物、衣料品添加物などに多く使われている 非常に身近でほぼ無害な安全性を備えた物質です。
![01.What is a photocatalyst? ―光触媒って、何?]()
02.私たちの光触媒 「CLEANEST NFE2」はここが違う!
私たちがご提案している光触媒「CLEANEST NFE2」は他にはない大きな特徴を持った特別な光触媒です。
非常に強力で一歩先行く光触媒です。
◇除菌
◇抗菌
◇抗ウィルス
◇消臭
◇防汚
◇防カビ
◇コーティング
「金属銅」&「金属銀」の混合に成功した唯一無二の光触媒!
光触媒に銅粉、銀粉を混ぜ合わせ、他にはないオリジナルで強力な抗ウィルス効果を持ったコーティング剤です。(現在特許出願中)
光触媒にNafion(フッ素系イオン交換樹脂)も混合し高稼働率を実現。(特許品)
本来の光触媒は除菌の効果はなく、酸化チタンと銀による消臭・防汚効果を期待され汚れない壁材・タイルとして注目されていました。
現在は幾度となく重ねられた研究により日本が生んだウィルスを不活化する技術として注目を集めています。
弊社の取り扱う「CLEANEST NFE2」で抗ウィルス空間をつくり、室内での接触感染リスクが抑えられると私たちは考えています。
特願2018-042131(特許6539370号)特願2016-212027(審査請求中)特願2017-077273(審査請求中)
![02.私たちの光触媒 「CLEANEST NFE2」はここが違う!]()
03.今日までこんな悩み、ありませんでしたか?
ウィルスに対しての恐怖心から「触れる」ということに神経質になってしまった。
職場の清掃がより細かく細分化されたことによる効率の低下。
消毒液等の購入による経費の圧迫。
自分は感染予防をしているが周りの人もしているのか?
高齢者・持病を持っている家族と同居している。
不特定多数の方が集まる環境のためウィルス感染が心配。
小さなお子様がいて、おもちゃなど口にしてしまうので感染リスクが心配。
テレワーク、リモートだけでは限界を感じる。
どのウィルス対策が正しいのか、あっているのかわからない。
質の高いウィルス対策を探していた。
そういった悩みは「CLEANEST NFE2」が解決します!
実演にて商品の実力をご紹介いたします。
実験動画もご紹介しています。
![03.今日までこんな悩み、ありませんでしたか?]()
04.「CLEANEST NFE2」には銅イオンが含まれているため銅による抗ウィルス効果は同等です。
インフルエンザウィルスやノロウィルスによる銅イオンの抗ウィルス実験
A型インフルエンザを銅(C1100)の表面に接触させ経時的に感染数を測定した結果、1時間後に接種量の75%相当のウィルスが死滅し、6時間後は0.025まで減少しました。(図左側)
銅自体が持つ殺菌効果は絶大です。
A型インフルエンザに対する抗ウィルス試験では、銅(C1020)の表面にウィルスを接触させ、経時後の感染価を計測した結果、銅の表面のウィルスは、30分作用後に検出限界値未満まで減少しました。
銅(C1020)がインフルエンザウィルスに対する感染症不活化に効果的であることが確認されました。

05.別の実験ではO-157に対しても効果を発揮。
1996年に猛威をふるい、外食産業の売上が急落するほどの混乱を巻き起こしたO-157。
このO-157に対し、銅が効果を発揮することが試験によりわかっています。
試験はシャーレにO-157の菌を含んだ寒天を入れ、その上に3cm角の銅板・黄銅板を置いて菌を培養、観測しました。
その結果、銅板・黄銅板のまわりでは菌の繁殖がくい止められ、真下では菌がまったく発育しないことがわかりました。
季節を問わず、身近な食品を通じて感染するO-157の怖さは、風化させてはならない問題です。
(右図)銅板の殺菌試験
使用菌株:病原性大腸菌O-157供試検疫:103CFU/ml
06.ウィルスや細菌等の除去(恐いレジオネラ菌に、銅の除菌効果)
近年、銭湯や温泉施設などでレジオネラ菌に感染し、命を落とすというニュースが世間の注目を集めました。
レジオネラ菌はもともと自然の中の土や水に生息する細菌で、循環式浴槽、給湯設備などの水や堆肥などから感染するとして恐れられています。
このレジオネラ菌に対する銅の殺菌試験を行いました。
試験は2つの方法で行いました。
ひとつは殺菌効果を試す試験で、水道用配管として使用されている銅、ステンレス、塩化ビニルの板にレジオネラ菌をまき、培養後の菌の数を測定しました。
その結果、試験片一枚あたり50万~60万CFUいた菌が、銅板では1000CFU以下に大幅に減少しました。
一方、ステンレス板、塩化ビニル板はほとんど減少しませんでした。
次に、銅イオン濃度と作用時間の関係を調べる試験では、段階的に濃度を変えた銅イオン溶液にレジオネラ菌を入れ、発生する菌の数を測定しました。
その結果、銅イオンの濃度と作用時間に比例して、殺菌効果が高くなることがわかりました。

07.防カビ作用
左の写真はかびの生えたコンクリート面の半分にそのまま塗布して放置したところの写真です。
特段の清掃や除かび作業なしでもカビの色素が脱色する現象が見られました。
塗布より5か月が経過しています。
右の写真は頑固に青カビの生えた石を採取して、その右半面に塗布して3日後の写真です。
清掃や除かび処置をしないでもかびが脱色していることが解ります。

08.世界初高機能光触媒で(除菌・抗菌・消臭)早めの対策を!
顕微鏡で成分を確認できます。
スマホ装着顕微鏡で必須成分の金属銅、金属銀粒を観察確認できます。
また画像記録として簡単に残せます。

09.成分別効果対応表
・消臭の即効性
・消臭の持続性
・抗ウィルス効果
・抗ウィルス持続性
・安全性
